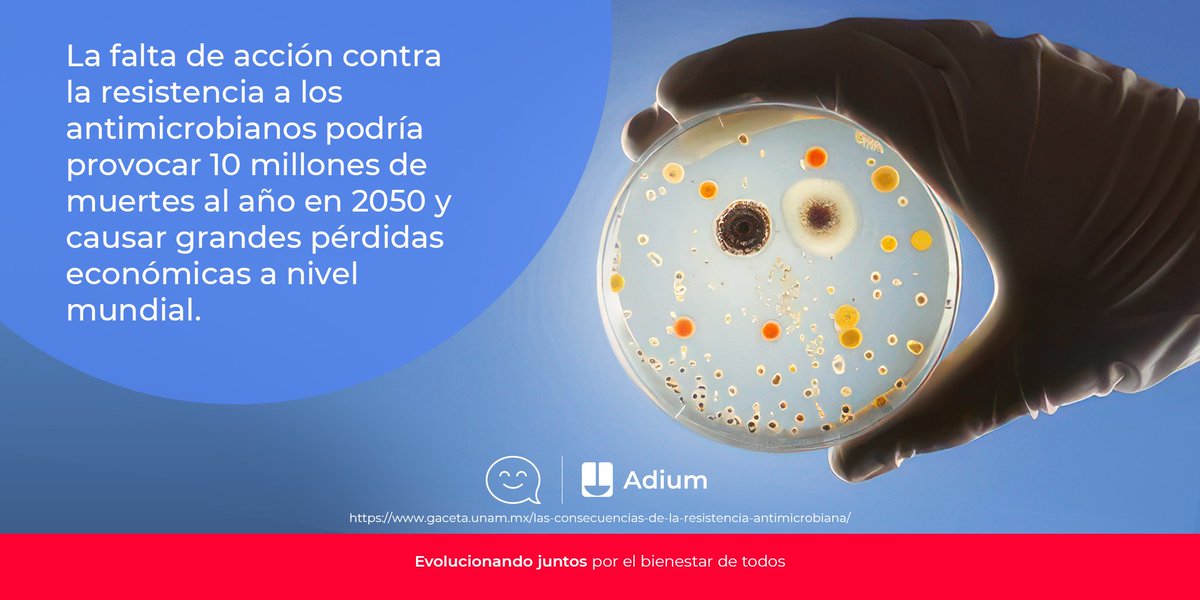

Adium México
@adiummx
Para nosotros, la pasión, compromiso, tecnología y altos estándares de calidad, son prioridad. Nuestra motivación eres tú. Permiso: 213300201B0441
ID: 1227008327885914112
https://www.adium.com.mx 10-02-2020 23:19:41
340 Tweet
199 Followers
7 Following